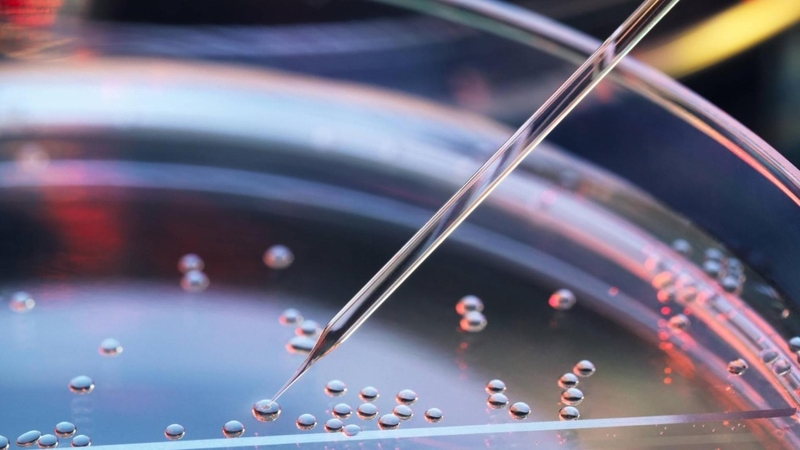
Tế bào gốc toàn năng: Đặc điểm và tiềm năng ứng dụng trong y học 1

Dược sĩ Đại học có nhiều năm kinh nghiệm trong việc tư vấn Dược phẩm và hỗ trợ giải đáp thắc mắc về Bệnh học. Hiện đang là giảng viên cho Dược sĩ tại Nhà thuốc Long Châu.
Thu Thủy
31/07/2025
Mặc định
Lớn hơn
Tế bào gốc toàn năng có tiềm năng lớn trong ứng dụng y học hiện đại. Bài viết dưới đây sẽ tổng hợp những thông tin cơ bản về khái niệm và đặc điểm của loại tế bào gốc này nhé!
Tế bào gốc toàn năng với khả năng biệt hóa thành bất kỳ loại tế bào nào trong cơ thể đã mở ra một giải pháp điều trị mới cho nhiều loại bệnh khác nhau. Hãy cùng Nhà thuốc Long Châu tìm hiểu về loại tế bào gốc này trong bài viết dưới đây nhé!
Tế bào gốc toàn năng (totipotent stem cells - TSCs) được xem là loại tế bào gốc linh hoạt nhất, có khả năng biệt hóa để phát triển thành toàn bộ phôi thai hoàn chỉnh. Loại tế bào này được thu nhận từ những lần phân chia đầu tiên trong quá trình phát triển của phôi, cụ thể ở giai đoạn từ 1 - 8 tế bào.

Tế bào gốc toàn năng chỉ tồn tại trong giai đoạn sớm của phôi thai và không có mặt trong cơ thể trưởng thành. Tế bào hợp tử lưỡng bội là một dạng tế bào toàn năng, xuất hiện trong ba lần phân chia đầu tiên của hợp tử trước khi đạt đến giai đoạn 16 tế bào. Quá trình phân chia và biệt hóa của tế bào gốc toàn năng dẫn đến sự hình thành các tế bào gốc phôi và tế bào gốc ngoài phôi, đóng vai trò nền tảng cho sự phát triển hoàn chỉnh của sinh vật.
Tuy nhiên, việc thu thập và nghiên cứu tế bào gốc toàn năng có thể đối mặt với các vấn đề pháp lý và đạo đức, đặc biệt khi sử dụng tế bào gốc từ phôi thai. Hiện nay, loại tế bào này chủ yếu được sử dụng trong nghiên cứu sinh học nhằm làm sáng tỏ các quy trình phát triển của cơ thể, từ đó mở ra những ứng dụng tiềm năng trong lĩnh vực y học và công nghệ sinh học.
Giao tử sau khi hình thành sẽ trải qua quá trình khử methyl (demethylation) trên toàn bộ DNA trong thời gian ngắn trên các gốc tế bào toàn năng, cùng với sự di chuyển linh hoạt của các histone. Khi các tế bào được phân hóa theo các chức năng cụ thể, gene sẽ được methyl hóa phù hợp với biểu sinh. Ở giai đoạn phôi hai tế bào (2C), quá trình khử methyl hoàn tất và giai đoạn này được xem là đại diện điển hình nhất cho tế bào gốc toàn năng, với khả năng tự tổ chức để phát triển thành phôi thai.
Để tạo ra tế bào gốc toàn năng, các nhà khoa học đã áp dụng nhiều phương pháp khác nhau. Trong số đó, kỹ thuật chuyển nhân từ tế bào soma vào trứng đã loại bỏ nhân đã gặt hái được thành công nổi bật với sự ra đời của cừu Dolly - động vật nhân bản vô tính đầu tiên. Ngoài ra, một phương pháp đáng chú ý khác liên quan đến việc sử dụng quần thể tế bào gốc phôi ở giai đoạn sau. Những tế bào này mang các yếu tố chuyển vị hoạt động tương tự như tế bào gốc toàn năng ở giai đoạn hai tế bào (2CLCs). Chúng được nuôi trong môi trường hạn chế biệt hóa để thu được tế bào gốc vạn năng.
Bên cạnh đó, quá trình khử methyl DNA từ tế bào sợi cũng được ứng dụng để tạo ra tế bào gốc toàn năng. Quá trình này giúp tái lập các đặc tính của tế bào gốc toàn năng tương đồng với tế bào trong phôi sớm, đặc biệt ở giai đoạn hai tế bào.

Để đảm bảo tính toàn năng, các nhà nghiên cứu đã xây dựng những tiêu chí cụ thể:
Quá trình nuôi cấy tế bào gốc toàn năng đòi hỏi phải được thực hiện tại các cơ sở y tế hoặc trung tâm nghiên cứu hiện đại, được trang bị đầy đủ công nghệ và máy móc tiên tiến. Đồng thời, quá trình này cần có sự tham gia của đội ngũ kỹ thuật viên, bác sĩ và chuyên gia giàu kinh nghiệm, có trình độ chuyên môn cao trong lĩnh vực tế bào gốc. Toàn bộ quy trình phải được tiến hành một cách khép kín, chuyên nghiệp, tuân thủ nghiêm ngặt các tiêu chuẩn khoa học để đảm bảo chất lượng và hiệu quả nuôi cấy.
Tế bào gốc toàn năng mang đến tiềm năng lớn trong ứng dụng y học hiện đại, đặc biệt ở lĩnh vực tái tạo mô và điều trị bệnh. Với khả năng biệt hóa thành mọi loại tế bào trong cơ thể, tế bào gốc toàn năng có thể được sử dụng để phát triển các liệu pháp thay thế, giúp tái tạo các mô hoặc cơ quan bị tổn thương. Điều này mang lại hy vọng lớn lao trong điều trị những bệnh lý khó chữa như các tổn thương thần kinh, bệnh tim mạch hay các rối loạn liên quan đến hệ miễn dịch.
Ngoài ra, tế bào gốc toàn năng còn đóng vai trò quan trọng trong nghiên cứu y học, giúp các nhà khoa học hiểu rõ hơn về cơ chế phát triển của cơ thể và nguồn gốc các bệnh lý. Các ứng dụng tiềm năng bao gồm việc thử nghiệm thuốc, phát triển các liệu pháp gene hoặc tạo ra mô và cơ quan trong phòng thí nghiệm để cấy ghép.
Tuy nhiên, việc ứng dụng tế bào gốc toàn năng vẫn đối mặt với nhiều thách thức, như các vấn đề đạo đức khi sử dụng phôi thai để lấy tế bào, cũng như rủi ro về biệt hóa không kiểm soát. Dù vậy, nếu khai thác hiệu quả và vượt qua được những rào cản này, tế bào gốc toàn năng có thể mở ra kỷ nguyên mới cho y học hiện đại, mang đến những bước tiến đột phá trong điều trị và cải thiện chất lượng cuộc sống.
Tế bào gốc toàn năng không chỉ mang lại những hiểu biết sâu sắc về sự phát triển và cơ chế hoạt động của cơ thể, mà còn mở ra cơ hội phát triển các phương pháp điều trị đột phá trong y học hiện đại. Mặc dù vẫn còn nhiều thách thức cần vượt qua, tiềm năng của tế bào gốc toàn năng trong việc tái tạo mô, thử nghiệm thuốc và điều trị bệnh lý phức tạp là không thể phủ nhận.
Xem thêm: Tế bào gốc vạn năng cảm ứng và tính ứng dụng trong y học
Dược sĩ Đại họcNguyễn Mỹ Huyền
Dược sĩ Đại học có nhiều năm kinh nghiệm trong việc tư vấn Dược phẩm và hỗ trợ giải đáp thắc mắc về Bệnh học. Hiện đang là giảng viên cho Dược sĩ tại Nhà thuốc Long Châu.